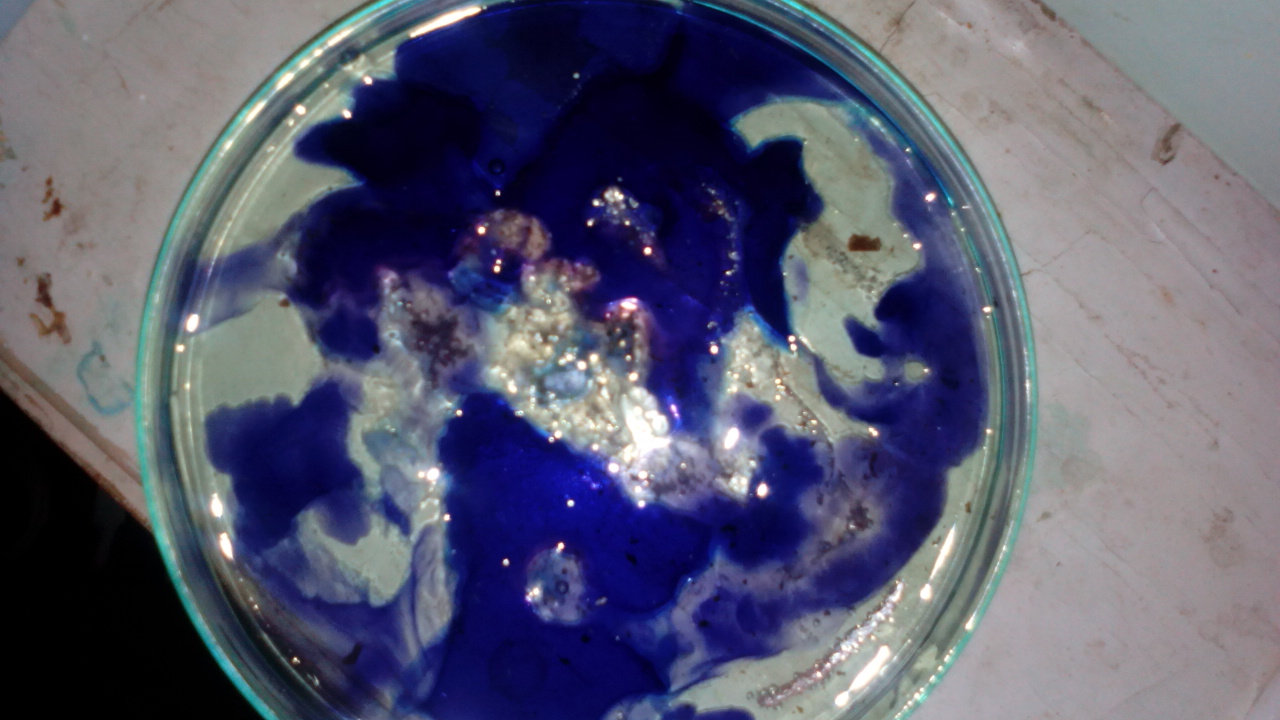

Xrpdguy
Hazard to Self
 
Posts: 51
Registered: 28-2-2018
Location: Serbia
Member Is Offline
Mood: Suspicious
|
|
Mixture of HCl+H2O2 with transition elements
Hello guys, today i mixed 28% HCl with 30%H2O2. Is this equation ok?
HCl+H2O2=HClO+H2O
Then i put some amount of elemental copper (from wires) and reaction was quite slow, but after some time it become very vigorous (with a lot of heat
and bubbling). At the end solution was deep green and after few minutes it become light blue.
2HClO+Cu=Cu(ClO)2+H2
Is Cu(ClO)2 in the solution or CuCl2*3H2O
In the other experiment i put iron nails into the same mixture, reaction was extremely vigurous and the solution was deep orange at first, but after
some time it become dark green.
Why is this happened? Is it by oxidation of oxygen from the air?
Oh dear, a lot of questions... 
|
|
|
woelen
Super Administrator
        
Posts: 8146
Registered: 20-8-2005
Location: Netherlands
Member Is Offline
Mood: interested
|
|
HCl hardly reacts with H2O2 to give HOCl. HOCl and HCl cannot coexist in large concentrations. Under such conditions you get Cl2 and H2O.
The real reaction between H2O2 and HCl is remarkably complex. There is oxidation of HCl by H2O2 to Cl2 and water, but Cl2 in turn can also produce
oxygen and HCl with H2O2.
The net reaction will be partial oxidation of HCl to Cl2 and water, but also decomposition of H2O2 to H2O and O2. You get a gas-mix of Cl2 and O2, but
the intermediate steps in the reaction are very complex and you even can get an oscillating reaction. At one time there may be vigorous bubbling, some
time later hardly anything seems to happen and then there is a burst of bubbling again.
-----------------------------------------------------------
If you add copper to such a mix, then you get the deep green/yellow CuCl4(2-) ion in concentrated acid. When the concentration goes down, then you get
CuCl2, dissolved in water, which gives blue hydrated Cu(2+) ions. There will be no ClO(-) in solution and you certainly won't get Cu(ClO)2.
If you use excess copper, relative to the hydrogen peroxide, all in conc. HCl, then you get very dark brown, nearly black solutions. Excess copper
metal will react with the copper(II) complex in the solution:
Cu + CuCl4(2-) ---> 2 CuCl2(-)
The right complex contains copper(I), this is a colorless complex. This complex in turn reacts with remaining copper(II) in solution, giving a dark
brown mixed-oxidation state complex, having simplified formula ClCu(μ-Cl)CuCl. This contains copper in oxidation state +1½.
------------------------------------------------------------
The experiment with the nail most likely is due to impurity in the iron. With pure iron I would expect a deep yellow/brown solution, containing the
complex FeCl4(-). The dark green color almost certainly is from chromium in the nail, or maybe nickel. Using nails for chemistry experiments is not a
good idea, they contain so much impurities that observations, based on experiments with them, do not tell anything useful. Copper wire (used for
electricity), however, is a very nice reagent, it is very pure copper (usually better than 99.9%).
Your HCl should be colorless. If it is yellow or brown, then it contains a lot of impurities.
|
|
|
Xrpdguy
Hazard to Self
 
Posts: 51
Registered: 28-2-2018
Location: Serbia
Member Is Offline
Mood: Suspicious
|
|
Thanks for answer @woelen, but after standing iron solution became yellow-brownish. Where are all those impurities and their colours?
Copper solution is still blue.
As i said in one my topic about complexes, i am really into that.
So, i mixed solution of sodium-benzoate with 30% H2O2 and nothing happened. Then i mixed it with a mixture of iron and copper which i obtained before
(see the previous post)- i thought about linking benzoate rings with two different metals, as metal centers.
At first purple-brownish precipitate occured, but after some time it became to bubble and reaction became vigurous with a lot of bubbling, heat and
steam (i think it was a steam). At the end the solution in the glass was intense yellow.
What happened? Did i make some unstable complex? or precipitate was a catslyst
of decomposition H2O2? or precipitate was a catslyst
of decomposition H2O2?
I also have a photos, but i am still trying to find a way to post it here.
Any help about unploading in U2Uwill be appreciated.
|
|
|
woelen
Super Administrator
        
Posts: 8146
Registered: 20-8-2005
Location: Netherlands
Member Is Offline
Mood: interested
|
|
With the iron, when you did not add sufficient acid, then you also can get a bluish compound. If you mix ferric ions and ferrous ions and then add
carbonate or hydroxide, then you get a dark blue/grey precipitate, which is a mixed oxidation state hydroxide, containing both iron(II) and iron(III).
On standing in contact with air, it slowly turns brown, when all iron(II) is oxidized to iron(III).
I would siggest you to read about complex ions and their colors. Also try to keep experiments as simple as possible. So, do not use mixes of (possibly
impure) iron salts and copper salts in your first experiments. First try to understand their behavior as single chemicals. This makes interpretation
of results easier.
The following pages from my website may help you get some understanding and a good starting point:
http://woelen.homescience.net/science/chem/exps/magnetite/in...
http://woelen.homescience.net/science/chem/riddles/copperI+c...
|
|
|
woelen
Super Administrator
        
Posts: 8146
Registered: 20-8-2005
Location: Netherlands
Member Is Offline
Mood: interested
|
|
Uploading pictures can be done by using the full editor (you get that by clicking the preview post button) and then at the bottom you see the
attachment option, with which you can add files. Preferrably keep files small (not more than 800x600 pixels, although technically you can upload
larger images).
|
|
|
Rhodanide
Hazard to Others
  
Posts: 348
Registered: 23-7-2015
Location: The 80s
Member Is Offline
Mood: That retro aesthetic
|
|
Quote: Originally posted by Xrpdguy  | Hello guys, today i mixed 28% HCl with 30%H2O2. Is this equation ok?
HCl+H2O2=HClO+H2O
Then i put some amount of elemental copper (from wires) and reaction was quite slow, but after some time it become very vigorous (with a lot of heat
and bubbling). At the end solution was deep green and after few minutes it become light blue.
2HClO+Cu=Cu(ClO)2+H2
Is Cu(ClO)2 in the solution or CuCl2*3H2O
In the other experiment i put iron nails into the same mixture, reaction was extremely vigurous and the solution was deep orange at first, but after
some time it become dark green.
Why is this happened? Is it by oxidation of oxygen from the air?
Oh dear, a lot of questions...  |
Hey rpdguy, regarding the color changes that you saw, that's normal. You
made CuCl2 by rxn of Cu + H2O2 + HCl. No Hypochlorous acid was made in any appreciable amount, that's not how those
two chemicals react. Copper Hypochlorite doesn't exist either, to my knowledge. With the Iron, you made either FeCl2, or Ferrous Chloride,
the green color, which was then Oxidized by O2 in the air to FeCl3, which was the orange color. You probably got a LOT of
Cl2 coming off when you did this, yes?
SO! To recapitulate: Copper + HCl + H2O2 = CuCl2 (Unbalanced & unfinished equation) | Iron + HCl +
H2O2 = FeCl3 (unbalanced & unfinished equation) | OR... Fe + 2HCl = FeCl2 + H2. Hope this
clears things up!
-Rhodanide
|
|
|
AJKOER
Radically Dubious
    
Posts: 3026
Registered: 7-5-2011
Member Is Offline
Mood: No Mood
|
|
Biochemist now believe that Cuprous in the present of chloride with dilute H2O2 (created by the living organism) will form some HOCl (see, for
example, https://www.ncbi.nlm.nih.gov/pubmed/3009503 and http://pubs.rsc.org/en/content/articlelanding/2016/cc/c5cc07... ).
There could be a fenton-like reaction between a soluble cuprous complex and H2O2 forming hydroxyl radicals which could lead to some hypochlorous acid:
Cu(l) + H2O2 --> Cu(ll) + •OH + OH-
Cl- + •OH = •Cl + OH- (presence of acid moves this and the above reaction to the right. A slow reaction with chloride, faster with bromide,..)
•Cl + Cl- = •Cl2- (increases with chloride concentration)
•Cl + •Cl = Cl2 (kinetically not likely)
Cl2 + H2O = HCl + HOCl
Per a source (no access, see https://pubs.acs.org/doi/abs/10.1021/jp036211i ), pertinent rate constants are available, to quote:
"The rate constants for the reactions Cl•(aq) + Cl2-•(aq) → Cl2(aq) + Cl-(aq) and Cl2-•(aq) + Cl2-•(aq) → Cl2(aq) + 2Cl-(aq) are
determined; rate constants for the latter are measured as a function of temperature and ionic strength."
Note, the •Cl2- radical is less reactive (than •Cl or •OH), but has greater longevity, and would be more of interest in contributing to the
formation of aqueous Cl2 and therefrom HOCl.
-----------------------------------------------------------
Also an oxygen, iron and copper possible path (an apparent Fe/Cu redox couple acting as a catalyst, Fe(ll) + Cu(ll) = Fe(lll) + Cu(l) ):
Half cell reactions (electrochemical cell):
Fe(ll) ---Copper ions--> Fe(lll) + e-
e- + O2 --> .O2-
Net reaction resulting in superoxide/.HO2/H2O2 formation:
Fe(ll) + O2 ---Copper ions--> Fe(lll) + .O2- (reference, see for example, http://pubs.acs.org/doi/abs/10.1021/ja01600a004 )
H+ + .O2- --> .HO2
.HO2 + e- --> HO2-
H+ + HO2- = H2O2
Cu(l)/Fe(ll) + H2O2 --> Cu(ll)/Fe(lll) + .OH + OH-
The formation of HOCl could follow from above with a chloride presence.
Interestingly, it has long been reported (like from Watts Dictionary of Chemistry) that HCl + H2O2 in very dilute conditions creates HOCl. This could
be explained, in my opinion, by a transition metal impurity in the water (see comments at https://www.sciencemadness.org/whisper/viewthread.php?tid=71... ).
[Edited on 1-5-2018 by AJKOER]
|
|
|
Xrpdguy
Hazard to Self
 
Posts: 51
Registered: 28-2-2018
Location: Serbia
Member Is Offline
Mood: Suspicious
|
|
Quote: Originally posted by Rhodanide  | Quote: Originally posted by Xrpdguy  | Hello guys, today i mixed 28% HCl with 30%H2O2. Is this equation ok?
HCl+H2O2=HClO+H2O
Then i put some amount of elemental copper (from wires) and reaction was quite slow, but after some time it become very vigorous (with a lot of heat
and bubbling). At the end solution was deep green and after few minutes it become light blue.
2HClO+Cu=Cu(ClO)2+H2
Is Cu(ClO)2 in the solution or CuCl2*3H2O
In the other experiment i put iron nails into the same mixture, reaction was extremely vigurous and the solution was deep orange at first, but after
some time it become dark green.
Why is this happened? Is it by oxidation of oxygen from the air?
Oh dear, a lot of questions...  |
Hey rpdguy, regarding the color changes that you saw, that's normal. You
made CuCl2 by rxn of Cu + H2O2 + HCl. No Hypochlorous acid was made in any appreciable amount, that's not how those
two chemicals react. Copper Hypochlorite doesn't exist either, to my knowledge. With the Iron, you made either FeCl2, or Ferrous Chloride,
the green color, which was then Oxidized by O2 in the air to FeCl3, which was the orange color. You probably got a LOT of
Cl2 coming off when you did this, yes?
SO! To recapitulate: Copper + HCl + H2O2 = CuCl2 (Unbalanced & unfinished equation) | Iron + HCl +
H2O2 = FeCl3 (unbalanced & unfinished equation) | OR... Fe + 2HCl = FeCl2 + H2. Hope this
clears things up!
-Rhodanide |
Thanks for answering, but there wasnt a lot of chlorine.
I agree with your reactions, but i am still not sure about the hydroxides, carbonates etc. which i obtained later from this chlorides.
For example, when i add conc. soultion od NaOH to iron solution it became black. After drying the yield looked like FeO.
Later i will upload photos.
|
|
|
Xrpdguy
Hazard to Self
 
Posts: 51
Registered: 28-2-2018
Location: Serbia
Member Is Offline
Mood: Suspicious
|
|
At last i made the photos 
1. The black one is probably FeO, cause in reaction with diluted HCl it turned green and some gas has been produced.
2. You can see the colours of copper and iron solution.
3.The solution in the blue glass should be magnesium chloride (cause you said that ClO- ions are not present in the H2O2+HCl mixture). I was curious
about a speed of the reacutions between earth alcali elements and transition ones, and there was a lot H2O2 so i tried to decompose it fast by adding
KMnO4 crystal and it looks like big mess now. 
4. In the right vial is the copper solution with few drops of KMnO4 solution (concentrated), just to decompose H2O2. This one doesnt look like the
previous. In the left one is 'something'. I tried to do change ions between copper solution and tin-lead alloy. I looked for tin, but after some time,
copper was on the bottom so i thought that reaction is over. Then i add conc. solution of NaOH to gain the hydroxide, but precipitation was yellow
(as lead-iodide). None of lead and tin doesnt have that precipitate except iodides. After standing it became blue.
    
|
|
|
woelen
Super Administrator
        
Posts: 8146
Registered: 20-8-2005
Location: Netherlands
Member Is Offline
Mood: interested
|
|
A yellow precipitate of copper is possible. When copper(II) is reduced to copper(I) in alkaline solution, then you get Cu2O. If this is formed very
slowly, then you get nice crystals, which are brick-red. If this is formed more quickly, then you get an orange, or even yellow, precipitate. The
solid then is hydrous Cu2O.
|
|
|
zed
International Hazard
    
Posts: 2312
Registered: 6-9-2008
Location: Great State of Jefferson, City of Portland
Member Is Offline
Mood: Semi-repentant Sith Lord
|
|
A little tidbit, albeit ancient, on HCl/H2O2 and Platinum.
https://archive.org/details/interactionofpla00shaf
Then, use of HCl/H2O and Gold.
https://www.youtube.com/watch?v=9SgUlLEuLuU
[Edited on 2-5-2018 by zed]
|
|
|
Xrpdguy
Hazard to Self
 
Posts: 51
Registered: 28-2-2018
Location: Serbia
Member Is Offline
Mood: Suspicious
|
|
Quote: Originally posted by woelen  | | A yellow precipitate of copper is possible. When copper(II) is reduced to copper(I) in alkaline solution, then you get Cu2O. If this is formed very
slowly, then you get nice crystals, which are brick-red. If this is formed more quickly, then you get an orange, or even yellow, precipitate. The
solid then is hydrous Cu2O. |
But that precipitate is unstable i think, cause after some time it become blue, as you can see in the left vial.
And whats about magnesium solution? I mixed 2ml of 30%H2O2 and 2ml of 18% HCl, then i add a piece of Mg. Reaction was pretty slow.
*Why does reaction of that mixture is faster with transition elements than earth alkaline (e.g. Mg)?*
After reaction i tried to get Mg(OH)2 by adding (drop by drop) NaOH solution (diluted). I spent about 10ml, but there wasn't a precipitate. By adding
drops a lot of bubbles were came out, like it decompose H2O2. Also bad idea (and 'short' nerves  ) was adding small KMnO4 crystal to the solution. ) was adding small KMnO4 crystal to the solution.
My question is: Why there wasnt a precipitate? Did i spend a whole NaOH for neutralisation? If yes, what i have neutraised?
|
|
|
Sulaiman
International Hazard
    
Posts: 3916
Registered: 8-2-2015
Member Is Offline
|
|
I've been doing hobby chemistry for four years now, almost all inorganic,
and I still do not really understand what I'm doing !
I think that the advice from woelen :
" try to keep experiments as simple as possible. So, do not use mixes of (possibly impure) iron salts and copper salts in your first experiments.
First try to understand their behaviour as single chemicals. This makes interpretation of results easier."
is excellent.
I have made a few mixtures of multiple reagents, expecting one thing but getting something else - usually a useless mix of waste products..
or, to re-phrase your own comment
"so i tried to XXX by adding YYY and it looks like big mess now."
was a common result for most of my random experiments. 
The interaction and preferred oxidation levels of elements is still baffling and amazing to me.
Understanding even what seem to be simple chemical equations is mind-boggling when you consider intermediate reactions/processes.
The good thing about chemistry is that there is always more to learn 
(and here is a good place to learn real chemistry)
CAUTION : Hobby Chemist, not Professional or even Amateur
|
|
|
Xrpdguy
Hazard to Self
 
Posts: 51
Registered: 28-2-2018
Location: Serbia
Member Is Offline
Mood: Suspicious
|
|
Quote: Originally posted by Sulaiman  | I've been doing hobby chemistry for four years now, almost all inorganic,
and I still do not really understand what I'm doing !
I think that the advice from woelen :
" try to keep experiments as simple as possible. So, do not use mixes of (possibly impure) iron salts and copper salts in your first experiments.
First try to understand their behaviour as single chemicals. This makes interpretation of results easier."
is excellent.
I have made a few mixtures of multiple reagents, expecting one thing but getting something else - usually a useless mix of waste products..
or, to re-phrase your own comment
"so i tried to XXX by adding YYY and it looks like big mess now."
was a common result for most of my random experiments. 
The interaction and preferred oxidation levels of elements is still baffling and amazing to me.
Understanding even what seem to be simple chemical equations is mind-boggling when you consider intermediate reactions/processes.
The good thing about chemistry is that there is always more to learn 
(and here is a good place to learn real chemistry)
|
I can understand you to the end. An inorganic chemistry is my big hobby and love. Haha in the most cases XXX with YYY isnt ZZZ, but XYZXYZYX 
I agree with you and @woelen about reactions and their complexion, but after four years on faculty and 8 years in the lab i saw and did a lot of
reactions in Organic and Inogranic and its easy to do some project when you have that explained in the books, but stuffs on this forum arent from the
books 
The most of these things you cannot find in the books or internet. E.g. on Google i cannot find anything about H2O2 and HCl mixture and its behaviour
with metals, even my professors arent sure about some parts and intermedieres. This is real science i think.
I like this forum because we can discuss about our interests and experiences. So i am sure we will rock this topic to the end very soon.
|
|
|
zed
International Hazard
    
Posts: 2312
Registered: 6-9-2008
Location: Great State of Jefferson, City of Portland
Member Is Offline
Mood: Semi-repentant Sith Lord
|
|
My concern is... Does this H2O2/HCl reaction, liberate Chlorine gas into the environment?
Since the reactant in these cases is Cl2 or Cl-.... Is it going to out-gas?
A little whiff of HCl is no big deal, a little whiff of Chlorine, can be very unhealthy.
|
|
|
Xrpdguy
Hazard to Self
 
Posts: 51
Registered: 28-2-2018
Location: Serbia
Member Is Offline
Mood: Suspicious
|
|
Quote: Originally posted by zed  | My concern is... Does this H2O2/HCl reaction, liberate Chlorine gas into the environment?
Since the reactant in these cases is Cl2 or Cl-.... Is it going to out-gas?
A little whiff of HCl is no big deal, a little whiff of Chlorine, can be very unhealthy.
|
Actually yes, i felt a little bit of chlorine. Maybe there was a lot of it, but i didnt see it in the beaker.
|
|
|
woelen
Super Administrator
        
Posts: 8146
Registered: 20-8-2005
Location: Netherlands
Member Is Offline
Mood: interested
|
|
Chlorine is not good to breathe, but it has excellent warning properties. You immediately smell it and it becomes very irritating when it reaches
dangerous levels. You then still have plenty of time to get away into fresh air. I would not worry about being poisoned to death by chlorine gas if
you work at a small scale (ml's and not tens of ml's of liquid). Just use common sense and try to avoid excessive breathing of the gas. A small whiff
of the gas is not a real issue, just don't stick your nose in a beaker full of chlorine gas 
Concentrated H2O2, mixed with concentrated HCl certainly gives chlorine gas, but also a lot of oxygen. You get some oscillatory reaction, with burst
of vigorous production of oxygen and periods which are much quieter during which there is (slow) production of Cl2.
@Xrpdguy: Several years of lab work is no guarantee of full understanding. I know someone who works in the lab for more than 15 years now as a
synthetic chemist (mainly organic), but he follows many 'recipes' and well-known paths to reach the desired goal. Textbooks contain a lot of important
and useful knowledge, but that knowledge is limited. Everyone follows the same well-known paths and that's why many other things are not known at all,
or somewhere hidden in old and obscure dusty journals, covered by years of time and being forgotten decennia ago. Even very common compounds, like
copper, combined with HCl, or copper, combined with thiosulfates, leads to extremely rich and complex chemistry, which is not described in textbooks,
but almost certainly is described in some old journal, for instance in the former USSR or pre-WW-II Germany. It is nearly impossible to find such
publications, only few people are interested in these things, because they have no direct commercial application.
Because of this complexity I have decided to adhere to a few rules:
- try to use pure chemicals (within reason and budget of course), not the hardware store stuff. On eBay you can find quite a few different chemicals
of good purity for decent prices.
- try to isolate effects and do not proceed before one effect is understood (or at least well-observed and described by you)
- when results become vague, due to addition upon addition of chemicals, quit and start over again.
- select chemicals carefully, so that only one ion/molecule is adding to the reaction. Other ions/molecules in the compound should be spectator
ions/molecules. E.g. if studying copper chemistry in sulphuric acid, use copper sulfate and not copper chloride, in order to avoid interference of the
newly added species. A safe starting point in dilute aqueous chemistry is that sulfate ion and in most cases also nitrate ions are spectator ions.
- be VERY precise in observing. Colors which are just a little bit different from what you expect can mean that you used impure stuff, but it can also
mean that you found something really interesting. An example of the latter can be read here: http://woelen.homescience.net/science/chem/riddles/iodide+su... . I noticed (from other experiments) that iodine, when reduced by acidified
sulfite never becomes completely colorless, it always remained a little yellow. This puzzled me.
|
|
|
Xrpdguy
Hazard to Self
 
Posts: 51
Registered: 28-2-2018
Location: Serbia
Member Is Offline
Mood: Suspicious
|
|
Hello again,
I did an experiment again. Now with P.A. grade of purity.
I used dry and clean Petri dish to make a big area for the reaction (its hard to obeserve it in the beaker or test tube).
Now i mixed 2ml of 16%HCl (p.a.) with 2ml of 30%H2O2. Within a second i felt a little bit of chlorine, but it desapeared very fast. Then i placed
three copper wires, very thin and clean. The reaction starts immediately with some tiny bubbles around the wires.
*That was Chlorine or Oxygen in the bubbles?*
The reaction was faster around the middle wire cause it was longer than other ones. In one moment the solution around the wires became dark blue,
almost black. ( I think it was just a high concentration of Cu2+ ions around of it), so i stirred the solution and connected all wires. In that moment
the reaction became very fast and there was a lot of chlorine.
I also checked for oxygen by stick, but the flame just above the reaction was intense blue and i lost it very soon, so there wasnt an oxygen.
When all of copper was dissolved, the reaction immediately stopped, so i think that copper is react two or three times faster then other reactants.
Then i added a big chunk of copper and it started again.
A good way to slow down the reaction is cooling ( i added 5ml of NH4NO3 conc. solution into mixture) or cool it with ice water bath.
*Can we make an equation now?*
        
|
|
|
AJKOER
Radically Dubious
    
Posts: 3026
Registered: 7-5-2011
Member Is Offline
Mood: No Mood
|
|
My take on the chemistry along with other pundits, as I cited in my comments above, is apparently a bit off, per very recent research!
Per this source: 'Activation of Oxygen and Hydrogen Peroxide by Copper(II) Coupled with Hydroxylamine for Oxidation of Organic Contaminants', by
Hongshin Lee†§, Hye-Jin Lee§, Jiwon Seo§, Hyung-Eun Kim§, Yun Kyung Shin‡, Jae-Hong Kim†, and Changha Lee, Department of Chemical and
Environmental Engineering, Yale University and Ulsan National Institute of Science and Technology, published very recently in Environ. Sci. Technol.,
2016, 50 (15), pp 8231–8238, DOI: 10.1021/acs.est.6b02067, per the abstract:
"This study reports that the combination of Cu(II) with hydroxylamine (HA) (referred to herein as Cu(II)/HA system) in situ generates H2O2 by reducing
dissolved oxygen, subsequently producing reactive oxidants through the reaction of Cu(I) with H2O2. The external supply of H2O2 to the Cu(II)/HA
system (i.e., the Cu(II)/H2O2/HA system) was found to further enhance the production of reactive oxidants. Both the Cu(II)/HA and Cu(II)/H2O2/HA
systems effectively oxidized benzoate (BA) at pH between 4 and 8, yielding a hydroxylated product, p-hydroxybenzoate (pHBA). The addition of a radical
scavenger, tert-butyl alcohol, inhibited the BA oxidation in both systems. However, electron paramagnetic resonance (EPR) spectroscopy analysis
indicated that •OH was not produced under either acidic or neutral pH conditions, suggesting that the alternative oxidant, cupryl ion (Cu(III)), is
likely a dominant oxidant."
Basically, Cu(l) formed by the action of H2O2 on Cu(ll), reacts with H2O2 to create the highly active Cu(lll) ion:
Cu(l)L + H2O2 --> Cu(lll)L' + Products (see drawing at https://pubs.acs.org/doi/abs/10.1021/acs.est.6b02067 )
In a system with chloride (no hydroxylamine), the role of the chloride is to complex the Cu(l) forming Cu(l)L.
|
|
|
AJKOER
Radically Dubious
    
Posts: 3026
Registered: 7-5-2011
Member Is Offline
Mood: No Mood
|
|
Quote: Originally posted by AJKOER  | My take on the chemistry along with other pundits, as I cited in my comments above, is apparently a bit off, per very recent research!
Per this source: 'Activation of Oxygen and Hydrogen Peroxide by Copper(II) Coupled with Hydroxylamine for Oxidation of Organic Contaminants', by
Hongshin Lee†§, Hye-Jin Lee§, Jiwon Seo§, Hyung-Eun Kim§, Yun Kyung Shin‡, Jae-Hong Kim†, and Changha Lee, Department of Chemical and
Environmental Engineering, Yale University and Ulsan National Institute of Science and Technology, published very recently in Environ. Sci. Technol.,
2016, 50 (15), pp 8231–8238, DOI: 10.1021/acs.est.6b02067 ........
........
Basically, Cu(l) formed by the action of H2O2 on Cu(ll), reacts with H2O2 to create the highly active Cu(lll) ion:
Cu(l)L + H2O2 --> Cu(lll)L' + Products (see drawing at https://pubs.acs.org/doi/abs/10.1021/acs.est.6b02067 )
|
The reaction appears to proceed either rapidly in steps depending on conditions, as I first possibly outlined originally:
Cu(l)L + H2O2 --> Cu(ll)L' + .OH + OH-
Followed by:
Cu(ll)L' + .OH --> Cu(lll)L'' + OH- (see https://www.erudit.org/en/journals/rseau/1999-v12-n4-rseau32... )
Or, I suspect given the lack of detection of hydroxyl radicals, perhaps through the formation and decomposition of an intermediate:
Cu(l)L + H2O2 --> Cu(ll)L'OH* + OH-
Cu(ll)L'OH* --> Cu(lll)L'' + OH-
[Edited on 17-6-2018 by AJKOER]
|
|
|
woelen
Super Administrator
        
Posts: 8146
Registered: 20-8-2005
Location: Netherlands
Member Is Offline
Mood: interested
|
|
The bubbles at the copper wires are oxygen. This is due to catalytic decomposition of H2O2 by the copper species, present around the wire.
Now we can start gving equations:
Copper first is oxidized to copper(II) ions by the H2O2 and acid. The redodx-reaction is accompanied by a coordination reaction.
The simple high-school model equation is oxidation of copper metal to Cu(2+) ions and acid is used up:
Cu + H2O2 + 2H(+) ---> Cu(2+) + 2H2O
A more accurate description is the following:
Cu + H2O2 + 2H(+) + 4Cl(-) ---> CuCl4(2-) + 2H2O
Here you have a redox reaction, combined with formation of the tetrachloro-complex of copper(II). Because of the fairly low concentration of HCl in
your mix, you almost certainly also have partial complexes, with a mix of chloride and water ligands.
A nice retry would be to take 30% HCl, add just a little 30% H2O2 and then add copper. Then you will see the green/yellow color of the tetrachloro
complex.
Next, the tetrachloro-complex of copper(II) reacts with copper metal as follows:
Cu + CuCl4(2-) ---> 2 CuCl2(-)
Here you have a redox reaction with formation of copper(I), coordinated to chloride. This reaction only occurs in fairly concentrated solutions of
chloride ion. Without the stabilizing effect of the dichloro copper(I) complex you would not getr any copper(I) in the mix.
If there is still H2O2 present, then the CuCl2(-) will be oxidized to CuCl4(2-).
Finally, when there is excess copper metal, relative to the H2O2, then both complexes CuCl4(2-) and CuCl2(-) are present besides each other. These
complexes form a very dark green/brown, almost black mixed oxidation state complex of not well-established structure. This compound only exists in
solution, it is not possible to isolate it. it is believed to be a bridged chloro complex, with copper in oxidation state 1½.
CuCl2(-) + CuCl4(2-) ---> ClCu(μ-Cl)CuCl + 3Cl(-)
This bridged complex is very very dark. it decomposes when the solution is diluted with a lot of water. Snow-white CuCl precipitates in that case and
a pale blue solution of copper(II) remains.
|
|
|
Xrpdguy
Hazard to Self
 
Posts: 51
Registered: 28-2-2018
Location: Serbia
Member Is Offline
Mood: Suspicious
|
|
Thanks for answering but that equations are opening more questions, like " Why is flame above the mixture blue, if its only oxygen released?" Is the
flame of burning stick enough powerful to do an excitation of copper ions? (About 300°C that fire has, i think).
Anyway i am also very into growing crystals in gels, especially dendrimers by using electric current. So after this reaction i took a solution and
mixed it with gelatine (70 blooms). After standing there wasnt any crystal even by using 7v battery, so i put a 3ml of 5M Sodium-hydroxide soultion
and got blue precipitate immediately. After standing on air precipitate became dark blue, almost dark violete.
|
|
|
|